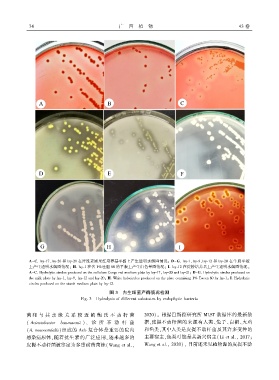

Page 78 - 《广西植物》2023年第1期
P. 78
7 4 广 西 植 物 43 卷
A-C. lzy ̄17、lzy ̄20 和 lzy ̄21 在纤维素刚果红培养基平板上产生透明水解圈情况ꎻ D-G. lzy ̄1、lzy ̄9、lzy ̄12 和 lzy ̄20 在牛奶平板
上产生透明水解圈情况ꎻ H. lzy ̄1 在含 1%吐温 80 的平板上产生白色晕圈情况ꎻ I. lzy ̄12 在淀粉培养基上产生透明水解圈情况ꎮ
A-C. Hydrolytic circles produced on the cellulose Congo red medium plate by lzy ̄17ꎬ lzy ̄20 and lzy ̄21ꎻ D-G. Hydrolytic circles produced on
the milk plate by lzy ̄1ꎬ lzy ̄9ꎬ lzy ̄12 and lzy ̄20ꎻ H. White halocircles produced on the plate containing 1% Tween 80 by lzy ̄1ꎻ I. Hydrolytic
circles produced on the starch medium plate by lzy ̄12.
图 3 内生细菌产酶情况检测
Fig. 3 Hydrolysis of different substrates by endophytic bacteria
菌 和 与 其 亲 缘 关 系 较 近 的 鲍 氏 不 动 杆 菌 2020)ꎮ 根据巴斯德研究所 MLST 数据库的最新数
( Acinetobacter baumannii )、 诊 所 不 动 杆 菌 据ꎬ皮提不动杆菌的来源有人类、兔子、白鹳、火鸡
(A. nosocomialis)组成的 Acb 复合体是重要的院内 和鱼类ꎬ其中人类是皮提不动杆菌及其许多变种的
感染病原体ꎬ随着抗生素的广泛应用ꎬ越来越多的 主要宿主ꎬ鱼类可能是其新兴宿主(Li et al.ꎬ 2017ꎻ
Wang et al.ꎬ 2020)ꎬ 目前还未见植物源的皮提不动
皮提不动杆菌被鉴定为多重耐药菌株(Wang et al.ꎬ